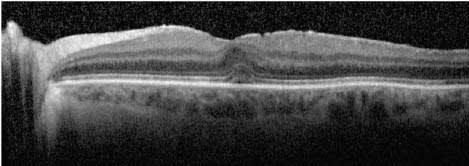
images

Is OCT Doing Enough For Your Practice?
A review of practical tips to maximize use of this device.
PAUL HAHN, MD, PHD, SANJAY ASRANI, MD
Optical coherence tomography — OCT — has had a profound impact on imaging of the posterior segment, initially for retinal disease and, more recently, for glaucoma. OCT imaging has become routine in many offices. In this article, we provide simple, practical tips to maximize use of the OCT machine in your office.
The Difficult-to-Assess Patient
OCT imaging can be surprisingly useful for situations in which ophthalmoscopy is limited. In patients with dense cataracts, which can make assessment of the posterior pole difficult, OCT can sometimes be the only way to identify subtle findings, such as macular thickening. The longer, near-infrared wavelength of current OCT machines scatters less than the visible spectrum, often resulting in better visibility than ophthalmoscopy through diffuse media opacities.
In patients with focal cataracts, OCT imaging can be directed around the opacity much more effectively than biomicroscopy (Figure 1). Other anterior segment opacities, such as corneal edema and corneal scars, may also prevent accurate fundus examination with ophthalmoscopy alone, but OCT can acquire adequate images even in these circumstances.
In addition, corneal scars or abnormalities may render measured IOP inaccurate. In these eyes, monitoring the glaucoma status is easier and more objective with serial measurements of the retinal nerve fiber layer (RNFL) thickness than comparing photographs of the optic nerve head.
Pediatric patients can also be difficult to examine. They often do not tolerate the bright lights of an ophthalmoscopic exam, and they may not sit still to allow the clinician to appreciate fine details. We must often be content with “sneaking a peek” at the posterior pole of young patients to rule out any gross abnormalities. Yet, children often tolerate the near infrared laser of OCT quite well compared to the bright white light of photography or ophthalmoscopy. With the rapid acquisition speeds of newer-generation spectral domain (SD)-OCT machines, adequate imaging of pediatric patients can often be easy to perform.


Figure 1. In this patient in whom a dense central lens opacity limited biomicroscopic observation, high-resolution OCT images demonstrated a normal macula by directing the OCT beam around the opacity.

Figure 2. In this patient with vision loss from dense vitreous hemorrhage and no view of the fundus in the right eye, examination of the left eye was performed (A). The horizontal (B) and vertical (C) “cross-hair” line scans through the fovea demonstrated a normal foveal contour and only a few subtle abnormalities of the retinal pigment epithelium. Examination of all scans throughout the macula was required to detect the presence of a large, extrafoveal, serous pigment epithelial detachment consistent with a diagnosis of polypoidal choroidal vasculopathy (D[OCT scan through green line in A]).
Optimize Scan Patterns
While OCT machines can acquire immense amounts of information, they are often programmed to acquire a limited number of scans, such as a vertical and horizontal “cross-hair” through the fovea. While this scan pattern is useful for fovea-affecting pathologies, many patients will have normal foveas with extrafoveal abnormalities. Current-generation SD-OCT devices can often obtain “volume” or “rectangular” scans that rapidly acquire linear scans across a volume spanning the entire macula, which is helpful in detecting macular pathology outside the fovea (Figure 2). We routinely acquire such volume scans and review each scan in the volume for every patient.


Figure 3. Peripherally directed OCT scans are useful in distinguishing between retinal detachment (A) and retinoschisis (B).
For glaucoma, having two anatomic structure measurements, such as the RNFL and the macular thickness or ganglion cell thickness, is helpful. Visualizing an abnormality in both these structures that correlates with the patient’s clinical findings gives more confidence to the clinician in establishing the diagnosis of glaucoma as well as confirming progression.
Additionally, obtaining a large area macular scan, such as a 8 × 8 mm posterior- pole scan, allows pattern recognition of the presence or absence of arcuate-shaped abnormalities typically representative of glaucoma. Abnormalities that are not arcuate in shape could arise from either neurological pathologies or retinal abnormalities.
Alternatively, the pathology of interest may not be located within the macula. While OCT is well suited for systems display the position of the scan on a high-reso-macular imaging, it can also be targeted peripherally. For lution scanning laser ophthalmoscopy (SLO) image. This example, in a patient with bullous retinal elevation, peripheral OCT can distinguish between retinal detachment and retinoschisis, affecting the decision to recommend surgery or observation (Figure 3, page 50).

Figure 4. In this patient with cystoid macular edema, resolution of thickening was clearly seen after six weeks of treatment, but further improvements in the next six weeks were difficult to detect by the OCT scans alone. The thickness maps and the numeric data confirmed initial improvement and were important in demonstrating ongoing improvement with continued treatment.

Figure 5. The scanning laser ophthalmoscopy image helped identify an epiretinal membrane and its borders (arrows). This membrane, and particularly its edges, were difficult to appreciate by ophthalmoscopy, standard fundus photography and even OCT.

Figure 6. The SLO image aided in identifying and documenting a faint disc hemorrhage (red arrow) that would have been otherwise difficult to appreciate.
Use Tools to Follow Pathology
While initial applications of OCT technology focused on detection of anatomic changes, such as cystoid macular edema, it quickly became apparent that OCT was also well suited to follow the temporal course of these changes. Most OCT machines include algorithms to measure central retinal thickness and calculate macular volume. These numeric data can be followed to quantify changes and identify subtle alterations. A thickness map that portrays topographic three-dimensional information – useful to visualize distributions of changes for both clinicians and patients (Figure 4, page 50) – easily represents these data. Note that the employed algorithms are different among machines; one should not compare numeric data between different machines.
Current-generation SD-OCT units have incorporated tracking into their acquisition protocols. In addition to minimizing movement artifacts, tracking enables exact comparison of individual scans from the identical location between visits. We use this feature almost exclusively when pathologic conditions need to be followed. We view registered and tracked OCT volume scans from the current and prior visit side-by-side in linked windows to scroll through the entire macular volume and identify even subtle changes in pathology throughout the macula.
Use Bells and Whistles
Advancements in OCT have resulted in increased functionality. While time-domain OCT systems display infrared fundus images whose use is limited primarily to localization of the position of the OCT scan on the fundus, SD-OCT systems display the position of the scan on a high-resolution scanning laser ophthalmoscopy (SLO) image. This SLO image maintains fine focus over a defined layer, which makes it useful in documenting and following pathology.

Figure 7. Multicolor SLO imaging may significantly enhance visibility of certain structures, such as this clearly highlighted epiretinal membrane.

Figure 8: The outer boundary of the retina was incorrectly identified due to geographic atrophy.
For example, SLO imaging clearly delineated the extent of a chronic retinal detachment that we were observing (Figure 3A, page 50). The SLO is acquired simultaneously with OCT scanning. Using the SLO to document fundus findings is particularly useful as reimbursement patterns typically do not allow for OCT imaging and fundus photography on the same day.
In addition, the SLO image can be useful in visualizing pathology that is otherwise difficult to see. For example, SLO images can highlight epiretinal membranes and their borders, often much more effectively than OCT imaging, fundus photography or even ophthalmoscopic examination (Figure 5, opposite page). Another example of the utility of the SLO image is its ability to demonstrate disc hemorrhages (Figure 6, opposite page), which, when they are subtle, are difficult to pick up clinically.
Current SLO images are typically acquired using a single wavelength near infrared laser source. The Spectralis SD-OCT (Heidelberg Engineering, Heidelberg, Germany) has a recently developed multicolor SLO that combines images from three different wavelength lasers, producing a pseudo-color SLO image that may provide even greater visibility of epiretinal membranes and other structures difficult to detect otherwise (Figure 7).
Autofluorescence is another multimodal option available on some SD-OCT units. Autofluorescence is commonly used in the quantification of geographic atrophy in AMD and as a screening tool for hydroxychloroquine toxicity. Applications for autofluorescence will likely continue to increase as ophthalmologists gain more experience with this modality.
Rule Out Artifacts
Like any other testing modality, OCT is subject to artifacts that one must rule out before accepting the results. We must examine raw images to ensure the data captured is of good signal strength and is centered in the window. Images of poor signal strength should be discarded and the eye should be re-imaged either with pupil dilation or after instilling artificial tears.
If the image is not centered in the window, part of the data might be truncated and, as a result, missing. Next, one must ensure the software-delineated boundaries of the structure measured are identified correctly. Misidentification of the upper (inner) boundary is common in patients with epiretinal membranes and with vitreous traction to the retina. Misidentification of the lower (outer) boundary is common with high myopia and peripapillary or geographic atrophy (Figure 8).
Clinical Tips
Clinical correlation must be made either with an evaluation of the clinical appearance of the retina, the nerve fiber layer in preperimetric glaucoma, or with disc cupping or visual fields in perimetric glaucoma. The patient usually greatly appreciates co-viewing the results, either digitally or in printed form, with the clinician.
Patients tend to believe more in objective tests rather than subjective ones such as ophthalmoscopy or visual fields. Their viewing of the OCT results helps improve compliance with the suggested treatment regimens. In those worried about the stage of their disease or the possibility of glaucoma or retinal disease progression, OCT can reassure them about the preservation of structures.
Conclusion
OCT is a promising and essential tool in the diagnosis and management of the majority of posterior segment conditions. Utilizing OCT to its maximum potential may be possible with the tips and pearls we have provided here. OM


|
Paul Hahn, MD, PhD, and Sanjay Asrani, MD, are with the Department of Ophthalmology, Duke University Eye Center, Durham, N.C. Disclosures: Dr. Hahn had no relationships to disclose. Dr. Asrani is a speaker for Heidelberg Engineering. |








